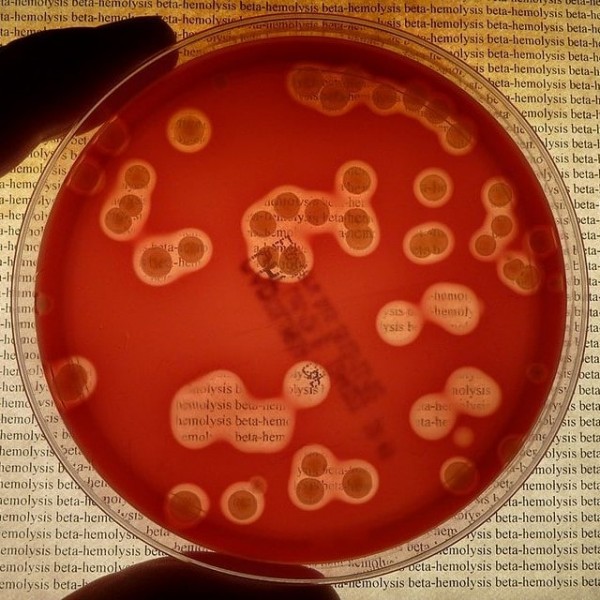
ما هو انحلال الدم

يمكن أن يظهر انحلال الدم لدى مختلف الفئات العمرية ونتيجةً لأسبابٍ بعضها مُكتسبة والبعض الآخر ينتقل عبر الجينات الوراثية من الوالدين وأوّل ما يظهر على الشخص من خلال بعض الأعراض والدلالات، حيث يفقد الجسم خلاياالدمالحمراء بشكلٍ أسرع من قدرته على تعويضها لذلك يصبح المريض بحاجةٍ إلى رعايةٍ صحيةٍ خاصة طيلة فترة حياته.
انحلال الدم
هو عملية تكسير خلايا الدم الحمراء نتيجةً لعوامل عدة ليتحرر الهيموغلوبين في الدم، ففي الحالة الطبيعية تعيش تلك الخلايا تقريبًا 120 يومًا وبعد موتها تتحلل في الطحال وتخرج من الدم، لكن في بعض الأحيان يزداد معدّل تكسير خلايا الدم الحمراء نتيجةً لحالاتٍ من التلف التي تُصيب صمامات القلب الاصطناعية أو في الطرق الواصلة بين الرئتين والقلب أو بسبب وجود عيوبٍ في الخلايا نفسها، كما قد يحدث ذلك بسبب تناول بعض أنواع الأدوية مثل الاسيتامينوفين والبنسلين وبعض مسكنات الألم، وأحيانًا يُصاب المريضبفقرالدم نتيجةً لتكسير خلايا الدم الحمراء ويُدعى بفقر الدم الانحلالي.
أسباب انحلال الدم
يحدث انحلال الدم نتيجةً للأسباب التالية:
أعراض انحلال الدم
تظهر على الشخص المصاب بانحلال الدم أعراضٌ مختلفةٌ كالبشرة الشاحبة والإحساس الدائم بالتعب والضعف العام والحُمّى إضافةً لعلامات التوتر والدوار والغضب، وقد يسبب انحلال الدم الجلطات الدموية وأمراض الكلى المزمنة والإصابة بفقر الدم المعروف باسم الأنيميا وكل هذا يُهدد حياة المريض.[2]
فقر الدم الانحلالي
هو أحد الأمراض الناتجة عن انحلال الدم حيث تتكسر خلايا الدم الحمراء بسرعةٍ أكبر من إنتاج الخلايا الجديدة فمن المعروف أن تلك الخلايا هي المسؤولة عن نقل الأكسجين إلى كافة أنحاء الجسم، فعند الإصابة بفقر الدم الانحلالي يكون عدد الخلايا أقل من العدد الطبيعي الضروري وبالتالي ستقلُّ نسبة الأكسجين الواصلة إلى مختلف أعضاء الجسم مما يؤثر على عملها أيضًا، إما أن يكون فقر الدم الانحلالي وراثيًا أي ينتقل من الوالدَين إلى الأبناء أو يكون مُكتسبًا حيث يُولد الطفل سليمًا لكنّه يُصاب به لاحقًا نتيجةً لسببٍ ما.
تشخيص انحلال الدم
أولًا يُجري الطبيب فحصًا سريريًا للمريض فينظر إلى الأمراض المُرافقة لانحلال الدم كشحوب الجلد، وقد يضغط في بعض مناطق البطن ليبحث عن وجود أي نوعٍ من التضخُّم في الكبد أو الطحال، لكن مع ذلك سيطلب إجراء بعض التحاليل المخبرية للدم للكشف عن وجود الانحلال:
العلاج
يمكن أن يقتصر علاج انحلال الدم والحالات المرتبطة به عن طريق عدة أساليب بعد الأخذ بعين الاعتبار عمر المريض وصحته العامة وتاريخ المرض وتطوره ودرجة المرض وسبب حدوثه والأدوية والعلاجات التي يستخدمها لأي مرضٍ كان، أما العلاج فيكون من خلال عدة أمورٍ:
انحلال الدم لدى الأطفال
قد يُصاب الأطفال بمرض انحلال الدم نتيجةً لأحد الأمراض الفيروسية:
المراجع
- 1 - Hemolysis: Symptoms & Signs , 1-7-2019 .
- 2 - What Is Hemolysis? – Definition, Causes & Symptoms , 1-7-2019 .
- 3 - Hemolytic Anemia: What It Is and How to Treat It , 1-7-2019 .
- 4 - Hemolytic Anemia , 1-7-2019 .
- 5 - Hemolytic Anemia: What It Is and How to Treat It , 1-7-2019 .